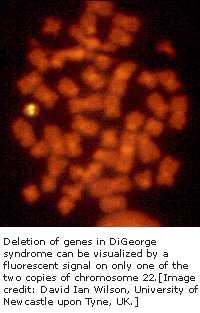
迪乔治综合症

第四节 迪乔治综合症
迪乔治综合症(DIGEORGESYNDROME)是一种罕见的先天性(例如,出身就有)疾病,个体之间临床表现差异很大,但最普遍的是包括经常发生感染史,心脏缺陷和面部结构特异。
迪乔治综合症是减数分裂(制造胚胎细胞和确认后代遗传差异的过程)重组发生差错,造成第22号染色体大量缺损所致。缺损意味着患有迪乔治综合症的病人在该区域中有几种基因不存在。出现疾病临床差异是与在染色体缺损中大量损失遗传物质有关。
虽然研究人员现在知道为正常发展胸腺和有关的腺体需要DGS基因,但扭转DGS的缺损是困难的。某些,例如心脏病患者和说话损伤者能通过外科或治疗获得效果,但免疫系统T—细胞(由腺体产生)的缺损是更具挑战性,并需对基因重组和免疫功能作进一步研究。
《基因与疾病》相关章节:
- ……
- 第十四节 希佩尔-林道病综合症
- 第二课 基因与免疫
- 第一节 哮喘
- 第二节 内分泌
- 第三节 肠炎疾病
- 第四节 迪乔治综合症(当前内容)
- 第五节 家属性地中海热
- 第六节 具有过量-lgM的免疫缺陷
- 第七节 严重的组合免疫缺陷
- 第三课 基因与代谢疾病
- ……


